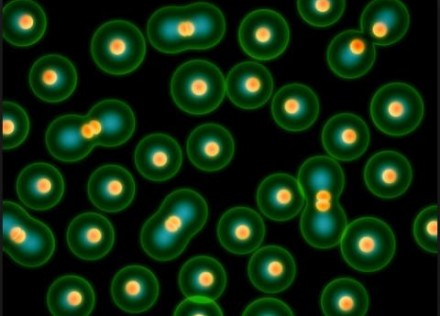

사람 진핵세포 대신할 합성 세포 만들어
과학자들이 첨단 기술을 적용해 사람의 세포와 유사한 인공세포를 만들기 시작했다. 20일 ‘사이언스’ 지는 미국 캘리포니아 대학의 생화학자 닐 드바라(Neal Devaraj) 교수 연구팀이 UCSD 연구진과 공동으로 사람의 진핵세포를 대신할 수 있는 합성 진핵세포(synthetic eukaryotic cell)를 만들고 있다고 보도했다. 진핵세포(eukaryotic cell)란 세포 내에 진정한 의미의 핵을 가지고 있는 세포를 말한다. 원핵생물을 제외한 원생생물계, 동물계, 식물계, 균계 등의 모든 생물들은 이 진핵세포를 가지고 있다. 이 진핵세포는 지질막(lipid membrane)으로 구성된 핵막으로 둘러싸여 있다. 연구팀은 지질막 대신 플라스틱인 아크릴산염 중합체(polymerized acrylate)를 원료로 살아 있는 세포와 유사한 핵막을 만들어내는데 성공했다.
합성생물학자들이 합성 물질을 원료로 인공 진핵세포를 제작하는데 성공해 세계적인 주목을 받고 있다. 사진은 미국 초등교육용 전자교과서에 게재된 진핵세포 모형도. ⓒck12.org
인공 진핵세포, 사람 세포처럼 신호 주고받아 드바라 교수 연구팀의 논문은 지난 16일 생물학 분야의 학술 데이터베이스인 ‘바이오아카이브(BioRxiv)’에 게재됐다. 논문 제목은 ‘Communication and quorum sensing in non-living mimics of eukaryotic cells’이다. 세포는 핵막이나 세포 소기관의 유무에 따라 원핵세포와 진핵세포로 구분된다. 원핵세포는 핵막이 없이 핵물질이 세포질에 퍼져 있어 세포 소기관이 존재하지 않는 세포를 말한다. 반면 진핵세포는 핵막이 있어 핵물질과 세포질이 구분되고 세포질에는 세포 소기관들이 존재한다. 원핵세포를 가진 생물을 원핵생물이라 하고 진핵세포를 가진 생물을 진핵생물이라 한다. 남조류와 세균이 원핵생물에 속하며, 아메바나 동식물을 비롯하여 우리가 알고 있는 대부분의 생물은 진핵생물에 속한다. 최근 과학자들은 세포의 기능을 만들어내는 세포핵은 2층의 지질막으로 구성돼 있는 핵막에 의해 둘러싸여 있으면서 세포질로부터 격리돼 있다는 사실을 발견했다. 이 핵막에 파묻혀있는 핵막공복합체는 단백질, RNA는 물론이고 이온 등의 저분자로부터 바이러스 등의 커다란 입자까지 세포핵과 세포질을 왕래하는 모든 물질의 유일한 통로가 되고 있다. 핵막공복합체의 구성인자도 밝혀지고 있다. 8방 대칭의 아름다운 기하학적인 구조를 취해, 1분 동안 수백 만 개가 넘는 방대한 수의 단백질을 정확하게 선택하고 통과시키는 기능을 지닌 것으로 알려져 있다. 드바라 교수팀이 만든 인공 진핵세포는 실제 핵막 속에 파묻혀 있는 핵막공복합체처럼 단백질을 통해 신호를 주고받으며 세포 활동을 하고 있다. 드바라 교수는 “세포 핵이 핵막을 통해 단백질 합성을 지시하는 RNA를 풀어놓으면서 세포 활동을 지시하고 있다”고 말했다. 이 세포핵은 다른 인공세포들로부터 보내진 신호를 인식하고 있는 것으로 확인됐다. 세포 핵막의 미세한 움직임 성공적으로 복제 최근 많은 과학자들의 연구 목표는 유전자 치료에 활용할 수 있는 인공세포핵을 만들어내는 것이다. 그런데 인공 세포가 실제 살아있는 세포처럼 활동하기 위해서는 진핵세포 기능을 수행할 수 있을 정도의 미세한 기능을 지닌 인공 핵막이 필요했다. 닐 드바라 교수 연구팀은 첨단 기술을 적용한 플라스틱 합성을 통해 살아있는 핵막을 대신할 수 있는 아크릴산염 중합체를 만들었다. 미네소타 대학의 생물학자 케이트 아다말라(Kate Adamala) 교수는 논문에 대한 코멘트를 통해 “드바라 교수팀이 만든 인공 핵막은 실제 핵막과 가장 유사한 인공 핵막이다. 이는 향후 합성생물학에 있어 가장 중요한 연구결과가 될 것”이라고 놀라움을 표명했다. 그동안 합성생물학자들은 ‘인공 세포(artificial cells)’를 만들기 위해 많은 노력을 기울여왔다. 그러나 리포솜과 같은 다른 합성구조체 들과는 달리 세포 내에서는 흉내를 내기 힘든 매우 민감한 움직임들이 다양하게 포착됐다. 합성생물학자들은 그러나 이 움직임을 파악해 인공 세포를 제작할 경우 보다 정교한 기능을 지닌 의약품을 생산할 수 있을 것으로 보고 있다. 또한 암을 비롯한 불치병 치료, 독성물질 감지, 특수 진단 시스템 등에도 큰 도움이 될 것으로 예상된다. 이번 연구를 주도한 드바라 교수는 합성물질(synthetic materials)을 사용해 인공세포를 만드는 일을 앞당길 수 있다고 보고 있다. 드바라 교수는 “당분(sugars), 과산화수소(hydrogen peroxide)와 같은 물질을 구성하고 있는 비교적 작은 분자들을 주고받을 수 있는 인공 핵막을 만드는데 성공하고 있다”고 밝혔다. 그러나 정교한 구조에 의해 사람의 면역시스템에 큰 영향을 미치고 있는 호르몬 인슐린(hormone insulin), 시토킨(cytokines) 같은 분자들을 주고받을 수 있는 인공 핵막은 아직 만들지 못한 상황이다. 드바라 교수는 이에 대해 “후속 연구를 진행해나가겠다”고 밝혔다. 이번 연구에 참여한 UCSD의 합성생물학자 헨리케 니더홀트메이어(Henrike Niederholtmeyer) 교수는 “연구팀이 제작한 인공 핵막은 실제 세포 모습과 유사하지만 전부 합성물질로 만들어졌다”고 말했다. 연구팀이 제작한 인공세포는 냉동상태에서 보관할 경우 2년 동안 건강한 상태에서 보존이 가능하다. 이 같은 지속적인 내구성은 향후 더 민감한 세포를 만들 수 있다는 가능성을 말해주고 있다. 현재 UCSD 연구팀은 이 인공세포를 의약품 개발 등 다른 분야에 적용할 수 있는 방안을 찾고 있는 것으로 알려졌다.
|